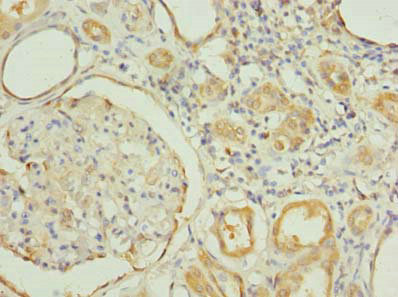
CSB-PA856927LA01HU

RNF31
RNF31(環(huán)指蛋白31),亦稱為ZIBRA或HOIP,是一種E3泛素連接酶,屬于RBR蛋白家族。它在進(jìn)化上高度保守,基因定位于人類14號染色體的14q11.2區(qū)域,編碼1072個氨基酸,分子量約為118kDa。RNF31在所有組織器官中均有低水平表達(dá),但在乳腺癌細(xì)胞中的表達(dá)水平顯著高于正常乳腺細(xì)胞,暗示其與腫瘤的發(fā)生發(fā)展相關(guān)。RNF31參與泛素化過程,即蛋白質(zhì)的翻譯后修飾,影響靶蛋白的氨基酸殘基,進(jìn)而參與多種生理功能,異常的泛素化表達(dá)可能促進(jìn)癌癥形成。 RNF31參與的信號通路包括NF-κB通路,其表達(dá)下調(diào)可抑制TNF-α刺激的NF-κB通路激活,影響細(xì)胞凋亡;TNF信號通路和Toll樣受體信號通路,這兩者在炎癥反應(yīng)和免疫應(yīng)答中至關(guān)重要;以及表皮生長因子受體(EGFR)信號通路,RNF31能夠調(diào)節(jié)EGFR及其下游信號,包括NF-κB、p-STAT3、MAPK和p-MAPK蛋白的表達(dá)。這些功能和信號通路的參與表明RNF31在細(xì)胞生長、免疫反應(yīng)和腫瘤發(fā)展中扮演著重要角色,其研究有助于開發(fā)新的癌癥治療策略,尤其是在乳腺癌和其他相關(guān)癌癥的治療中。
熱銷產(chǎn)品
RNF31 Antibody (CSB-PA856927LA01HU)
驗(yàn)證數(shù)據(jù)
Immunohistochemistry of paraffin-embedded human kidney tissue using CSB-PA856927LA01HU at dilution of 1:100

Immunofluorescent analysis of PC-3 cells using CSB-PA856927LA01HU at dilution of 1:100 and Alexa Fluor 488-congugated AffiniPure Goat Anti-Rabbit IgG(H+L)
RNF31 Antibodies
RNF31 for Homo sapiens (Human)
| 產(chǎn)品貨號 | 產(chǎn)品名稱 | 種屬反應(yīng)性 | 應(yīng)用類型 |
|---|---|---|---|
| CSB-PA856927LA01HU | RNF31 Antibody | Human | ELISA, IHC, IF |
| CSB-PA856927LD01HU | RNF31 Antibody, Biotin conjugated | Human | ELISA |
| CSB-PA856927LC01HU | RNF31 Antibody, FITC conjugated | Human | |
| CSB-PA856927LB01HU | RNF31 Antibody, HRP conjugated | Human | ELISA |
RNF31 Proteins
RNF31 Proteins for Mus musculus (Mouse)
| 產(chǎn)品貨號 | 產(chǎn)品名稱 | 來源 |
|---|---|---|
| CSB-YP846072MO CSB-EP846072MO CSB-BP846072MO CSB-MP846072MO CSB-EP846072MO-B |
Recombinant Mouse E3 ubiquitin-protein ligase RNF31 (Rnf31), partial | Yeast E.coli Baculovirus Mammalian cell In Vivo Biotinylation in E.coli |
RNF31 Proteins for Homo sapiens (Human)
| 產(chǎn)品貨號 | 產(chǎn)品名稱 | 來源 |
|---|---|---|
| CSB-YP856927HU CSB-EP856927HU CSB-BP856927HU CSB-MP856927HU CSB-EP856927HU-B |
Recombinant Human E3 ubiquitin-protein ligase RNF31 (RNF31), partial | Yeast E.coli Baculovirus Mammalian cell In Vivo Biotinylation in E.coli |
















